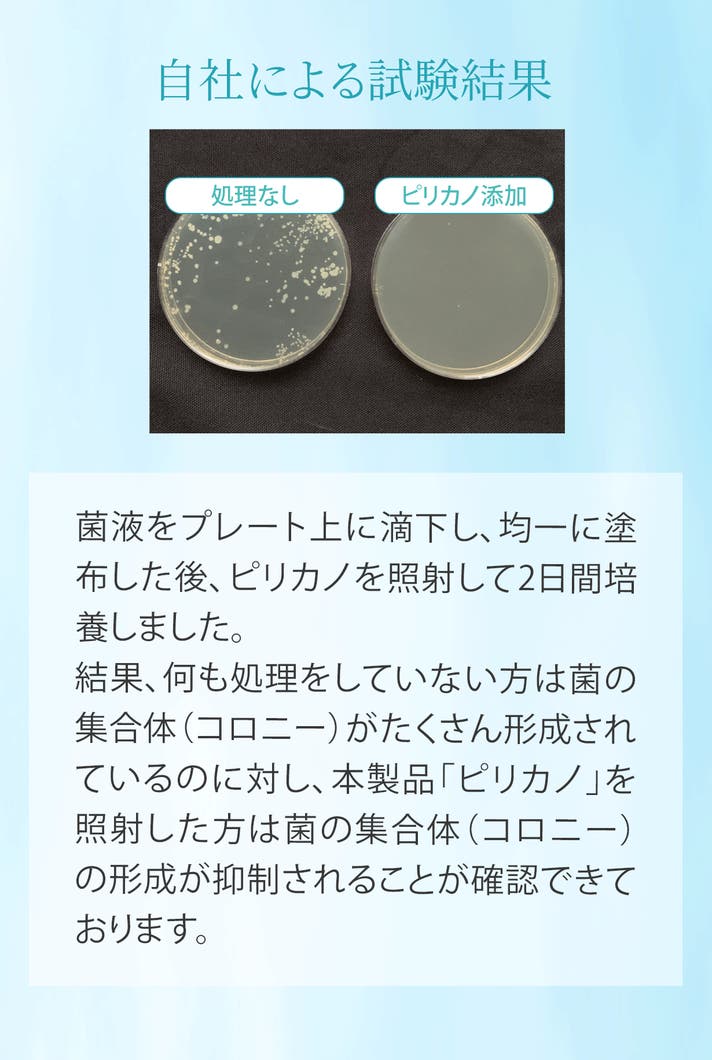

プロジェクト実行者
ストーリー
- 北海道で廃棄されるホタテ貝殻を除菌剤として生まれ変わらせました
- 原料は水とホタテの貝殻のみ。アルコール特有のニオイも、香料による香りもありません
- 自然由来の素材を活用したスプレーが、あなたの暮らしを「ピリカ(美しく)」します

北海道で大量に廃棄されるホタテ廃棄物(貝殻)を除菌剤として再活用するプロジェクトです。
除菌剤という生活で必要なものの成分はシンプルにしたい。でも清潔さは保ちたい。
そんなあなたへ贈る、北海道からの新しい提案です。
原料は「水」と独自の焼成技術で加工した「ホタテ貝殻」のみ。
アルコール特有のニオイや刺激もありません。
北海道の海から生まれた環境に優しいプロジェクト、皆様に応援いただければ幸いです。

▼使い方







(株)Shell Medは、廃棄物を有効利用する技術を開発し、自然の恵みを余すところなく活用することを目指しております。
今回の商品はその第一弾として、北海道で大量に廃棄されるホタテ貝殻を除菌剤に生まれ変わらせました。
現在当社では、除菌剤以外の貝殻の活用方法や、廃棄されるホタテ内臓の有効活用に関しても研究開発を進めております。
これらの技術開発により、資源循環社会の実現をより進めていきたいと考えております。
今回の製品を通じて、多くの皆様に(株)Shell Medの取組みを応援いただければ幸いです。

・長時間放置しているとカルシウムが沈殿することがあります。その際はよく振ってからご使用ください
・直接、手や顔など、肌には吹き付けないでくだい
・お子様の手の届かないところに保管してください
・皮革、合皮、エナメル、絹、和装品には使用しないでください
・色落ちしやすいもの等には使用 しないでください
・直射日光を避け、常温常湿の室内に 保管ください
・目に入った場合や誤飲してしまった場合はすぐに流水などで対処し、医師にご相談ください
・すべての菌を除菌できるわけではありません

Q.初期不良時を確認した時にはどうしたらいいですか?
A. Makuakeメッセージにてご連絡ください。状況を確認させていただき、商品交換/返金など対応させていただきます。
Q.白い粉が浮いている(あるいは沈殿している) のは不良品ですか?
A.時間の経過とともにカルシウム成分が沈降することがございます。その際は容器を拡販し、全体を均一にしてからご使用ください。
Q.pH試験紙を照射しても紫色にならないのですが(アルカリ性を示さない)
A.保存状態によっては空気中の二酸化炭素と反応して、炭酸カルシウムに戻ることがございます。その場合、お写真を添えてMakuakeメッセージにご連絡ください。購入後1か月以内におきましては商品交換にて対応させていただきます。

◆製造開始:2026年1月
貝殻の焼成および除菌剤製造および梱包作業を開始
活動レポートにて詳細状況をお伝えさせていただきます。
◆商品発送:2026年5月中旬以降
活動レポートにて詳細状況をお伝えさせていただきます。
リスク&チャレンジ
※容器やデザインは一部変更になることがあります。 ※使用感等に関する返品・返金はお受けいたしかねます。 ※応援購入後のキャンセルはお受けいたしかねます。 ※本⽂中に記載させていただいたスケジュールは、あくまでプロジェクト公開時点の 予定です。応援購⼊の性質上、配送遅延のおそれがございます。 原則として、配送遅延に伴う応援購⼊のキャンセルはできませんが、リターン配送 予定⽉から3ヵ⽉を超えた場合には、希望者に限りキャンセルにて対応させていただきます。 ※商品等の不具合による返品・交換に関しては、下記を参照ください。 ◾️対応条件: 商品の初期不良、またはお届けした商品がご注文内容と異なる場合、到着後7日以内にプロジェクトページの「実行者にメッセージ」よりご連絡ください。状況を確認の上、返金対応、または良品との交換対応をさせていただきます。 ◾️返金額: リターン金額(税込)の全額 ◾️返品送料/再送料: 実行者負担 【返品・交換をお受けできない商品】 ・サポーターの責任により破損、汚損が生じた商品 ・商品のタグ、付属品、パッケージ(箱、袋など)を紛失、破棄された商品 ・事前にご連絡をいただいていない商品 ・商品到着後、7日以上経過した商品 (ただしpH試験紙でアルカリ性を示さない場合は購入後1か月以内に限り商品交換させていただきます)
サポーターからの応援コメント
文章のトップに戻る
応援購入する
このプロジェクトはAll in型です。目標金額の達成に関わらず、プロジェクト終了日の2026年04月29日までに支払いを完了した時点で購入が成立します。
決済時に安心システム利用料として2.2%(税抜)がかかります。
インボイス(適格請求書):対応可
【Makuake早割】 ピリカノ お試しセットA
2,600円(税込)
・トリガースプレー(400ml)×1本
・詰替え(400ml)×1袋
・pH試験紙×2枚
【Makuake早割】 ピリカノ お試しセットB
3,420円(税込)
・ボトルスプレー(100ml)×1本
・トリガースプレー(400ml)×1本
・詰替え(400ml)×1本
・pH試験紙×2枚
※ボトルは小型のスプレーになります。カバンの中に入れて持ち運ぶことも可能なタイプになります。
【まとめ買い割】 ピリカノ しっかりセットA
4,680円(税込)
・トリガースプレー(400ml)×2本
・詰替え(400ml)×2袋
・pH試験紙×2枚
【まとめ買い割】 ピリカノ しっかりセットB
6,200円(税込)
・ボトルスプレー(100ml)×2本
・トリガースプレー(400ml)×2本
・詰替え(400ml)×2袋
・pH試験紙×2枚
※ボトルは小型のスプレーになります。カバンの中に入れて持ち運ぶことも可能なタイプになります。
【まとめ買い割】 ピリカノ 施設・業務用セットA
14,700円(税込)
・トリガースプレー(400ml)×5本
・詰替え(400ml)×10本
・pH試験紙×2枚
【まとめ買い割】 ピリカノ 施設・業務用セットB
17,850円(税込)
・ボトルスプレー(100ml)×5本
・トリガースプレー(400ml)×5本
・詰替え(400ml)×10本
・pH試験紙×2枚
※ボトルは小型のスプレーになります。カバンの中に入れて持ち運ぶことも可能なタイプになります。
「Makuake(マクアケ)」は、実行者の想いを応援購入によって実現するアタラシイものやサービスのプラットフォームです。このページは、 プロダクトカテゴリの 「【原料は水と貝殻のみ】北海道産ホタテの焼成パウダー使用。アルコール不使用の除菌剤」プロジェクト詳細ページです。